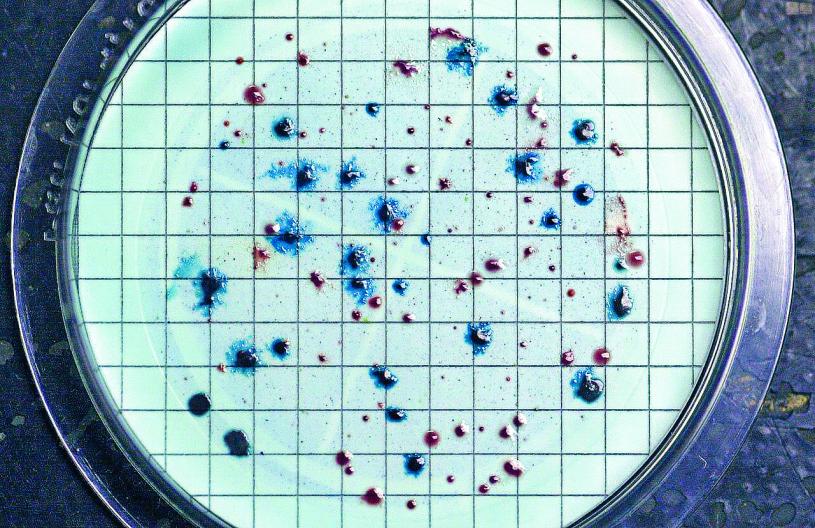

俄亥俄州和密歇根兩州爆發大腸桿菌感染潮,聯邦疾病預防及控制中心(CDC)正在調查感染源頭。
綜合《紐約時報》及克里夫蘭《誠懇家日報》報道,CDC仍在確定這次情況是否由食物引起,目前俄州出現14名患者,密州則有15人,兩地共有9人需住院,幸而暫時未發現死亡個案。
但是密州衛生部門同時表示,當局收到的病例數字遠超聯邦統計,8月期間已錄得98宗大腸桿菌病例,幾乎是去年同期20宗的5倍。州府的調查仍處於初步階段,實驗室已發現部分病例互有關聯,患者年齡由6至91歲不等。
密州首席醫療主任巴格達薩里安(Natasha Bagdasarian)發表聲明表示,雖然每逢夏天大腸桿菌的病例都會增加,但這次增幅令人擔憂,民眾若出現抽筋、腹瀉、腸胃不適等症狀,為了安全起見都應及時求醫,感染大腸桿菌的其他常見症狀,還包括嘔吐及發燒,民眾應該徹底清潔雙手,接觸食物時也需注意,藉此預防食源性病例。
根據CDC指引,民眾感染大腸桿菌後,通常在3至4天內出現症狀,大多數人無需治療,可在5到7天內自行康復,但個別人士可能會出現腎功能衰竭,並且需要住院。CDC呼籲民眾注意雙手、餐具及烹飪器具的清潔;處理蔬菜水果時用流水沖洗;確保生肉及海鮮遠離其他食物;烹調時以高溫殺死細菌,儘量降低患病風險。
衛生官員亦建議民眾,應在冰箱而不是桌面上解凍食物,同時避免飲用湖泊、池塘、溪流、游泳池及兒童水池的生水。
大腸桿菌普遍存在於腸道中,容易經糞便污染的食物而導致感染。去年全美發生同類病例,多數與包裝沙律、菠菜、蛋糕粉等食物有關,2019年受污染的羅馬生菜曾引發大腸桿菌疫情,27個州內167人染疫,其中85人住院,15人出現腎衰竭。本報訊